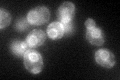
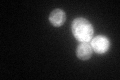

View description
Microsomal beta-keto-reductase; contains oleate response element (ORE) sequence in the promoter region; mutants exhibit reduced VLCFA synthesis, accumulate high levels of dihydrosphingosine, phytosphingosine and medium-chain ceramides
Localization:
Intensity:
Fold change:
Significance:
-
C’ GFP library in SD
ER58.1 -
N' NOP1pr-GFP in SD

punctate148.866 -
N' TEF2pr-mCherry in SD

punctate182.823 -
N' NATIVEpr-GFP in SD

missing0 -
N' TEF2pr-VC and Cyto-VN in SD

punctate26.4233 -
C’ GFP library in SD+DTT
ER61.671.06No -
C’ GFP library in SD+H2O2

ER74.881.28No -
C’ GFP library in Starvation Media

ER70.581.21No -
C’ GFP library on the background of Pup2-DaMP

ER -
C’ GFP library on the background of CCT mutant

ER62.56111.07669No
